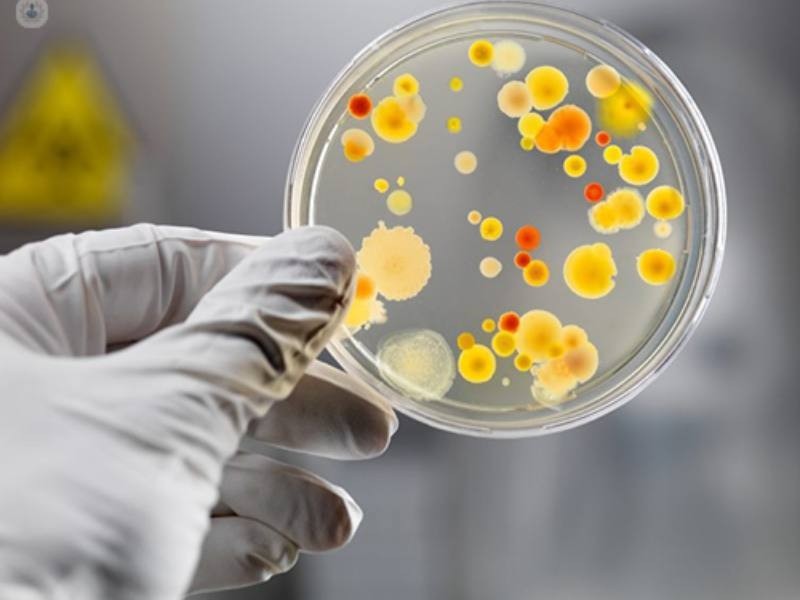
Infectologista Belém, Consulta Infectologista Belém - Clínica Rede Mais Saúde

A infectologia é a especialidade da medicina que estuda doenças infecciosas que atingem tanto adultos quanto crianças. Essas infecções podem ser causadas por bactérias, vírus, parasitas ou fungos que se multiplicam e causam danos ao organismo. O médico infectologista previne, diagnostica e trata doenças como dengue, HIV, Covid-19, pneumonia, toxoplasmose e tuberculose.
Nesta quinta-feira (11) é comemorado do dia do infectologista e a Agência Aids presta sua homenagem a todos os infectologistas e profissionais de saúde que estão na linha de frente combatendo o HIV e outras infecções.
Confira abaixo o perfil de três profissionais que fazem diferença na luta contra o HIV/aids
Jean Gorinchteyn
Gorinchteyn é infectologista do Hospital Emílio Ribas, considerado de excelência no combate ao novo coronavírus, e do Hospital Albert Einstein. É professor de infectologia na Universidade de Mogi das Cruzes, onde se formou há 30 anos. Tem ampla vivência profissional na área hospitalar, adquiridos como médico assistente, nas enfermarias e ambulatório do Instituto de infectologia Emílio Ribas e no Hospital São Camilo- Pompéia, desenvolvendo assistência aos pacientes portadores de doenças infecciosas.
Além disso, desenvolveu grande experiência na área de ensino, através de aulas e discussões clínicas com alunos do curso de medicina e estagiários do curso de enfermagem, nutrição e fisioterapia, ministrando aulas sobre a temática médica, incluindo aspectos clínicos, terapêuticos e saúde pública.
Também é mestre em doenças infecciosas pela Coordenação dos Institutos de pesquisa da Secretaria de Estado da Saúde de São Paulo e fez doutorado em neurologia experimental pela Unifesp (Universidade Federal de São Paulo). Desde 2019, Jean é embaixador do Instituto Trata Brasil, que apoia as ações pela universalização do saneamento. Na gestão de João Dória, foi secretário de Estado da Saúde de São Paulo.
Vinícius Borges (Doutor Maravilha)
Dr. Vinícius Borges é um nome que já se tornou referência em medicina infectologista, especialmente no atendimento à comunidade LGBT+. Nascido em 1987 na cidade de Ijaci, sul de Minas Gerais, desde cedo ele sabia que queria ser médico. Aos 18 anos, conseguiu ingressar na Faculdade de Ciências Médicas de Minas Gerais, onde se formou em 2011.
Após a graduação, o Dr. Vinícius decidiu que queria se especializar em Infectologia e começou sua residência no Hospital das Clínicas da UFMG. Durante a residência, ele descobriu sua verdadeira paixão pela infectologia e, após concluir a residência, optou por se especializar na área.
Em 2017, o Dr. Vinícius concluiu sua especialização em Infectologia na UFMG e começou a trabalhar como infectologista em um hospital de Belo Horizonte. Depois teve um ano de experiência como médico tropical no Tocantins.
Em 2019, o Dr. Vinícius decidiu se mudar para São Paulo em busca de novas oportunidades profissionais. Ele abriu um consultório particular na cidade e passou a atender pacientes de todas as idades e gêneros, mas com um foco especial na comunidade LGBT. Seu trabalho tem sido fundamental para melhorar a qualidade de vida desses pacientes, muitos dos quais enfrentam dificuldades para acessar serviços de saúde.
Além do seu trabalho como médico infectologista e criador do Doutor Maravilha, o Dr. Vinícius também é um defensor ativo dos direitos LGBT. Grande incentivador da educação sexual nas escolas, ele sabe que quanto mais informação os jovens tiverem sobre saúde sexual, mais preparados estarão para enfrentar os desafios da vida adulta.
Dr. Rico Vasconcelos
Médico Infectologista formado e especializado pela Faculdade de Medicina da USP, e residências médicas em Clínica Médica (2007) e Infectologia (2010) pelo Hospital das Clinicas da Faculdade de Medicina da Universidade de São Paulo.
Trabalha desde 2007 atendendo pessoas que vivem com HIV e com pesquisas clínicas no campo da prevenção de HIV e outras ISTs. É médico do SEAP HIV, ambulatório especializado em HIV do Hospital das Clínicas da FMUSP e participou de importantes estudos de PrEP, como o iPrEX e do Projeto PrEP Brasil.
Fez seu doutorado com PrEP e ISTs também na FMUSP e é coordenador médico do HPTN 083, o ensaio clínico da PrEP injetável de longa duração, e o MOSAICO, estudo da vacina preventiva contra o HIV. Participa no processo de formação de médicos residentes em infectologia do Hospital das Clínicas e de difusão de informação envolvendo atividades com alunos de graduação da USP, ONGs, portais de comunicação, agências de notícias e seminários de educação comunitária na temática de HIV e ISTs no Brasil.
É colunista da seção VivaBem do Portal UOL.
Redação Agência de Notícias da Aids


